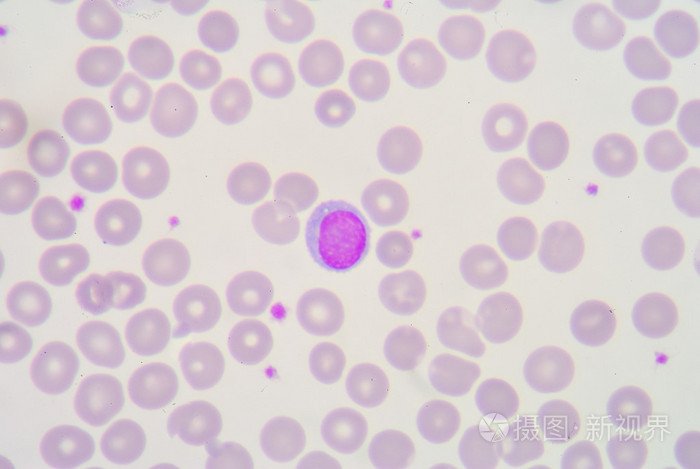
淋巴细胞

大淋巴细胞

淋巴细胞增多背后的原因大颗粒淋巴细胞
图片尺寸542x327
傻傻分不清的淋巴细胞
图片尺寸1000x750
淋巴细胞增多背后的原因大颗粒淋巴细胞
图片尺寸660x495
中间的淋巴细胞是成熟的吗
图片尺寸3264x2448
异型淋巴细胞反应性淋巴细胞
图片尺寸1920x1870
淋巴细胞
图片尺寸700x469
各种淋巴细胞及其它细胞
图片尺寸2000x2666
p>t淋巴细胞来源于骨髓的 a href="#" data-lemmaid="2056159">多能
图片尺寸500x400
淋巴细胞篇(形态)787878
图片尺寸1080x1439
颗粒淋巴细胞形态欣赏
图片尺寸750x1000
t细胞大颗粒淋巴细胞白血病
图片尺寸1779x1623
淋巴细胞b细胞
图片尺寸1500x1500
淋巴细胞
图片尺寸1100x1146
显微镜下的淋巴结细胞.
图片尺寸1200x800
淋巴细胞
图片尺寸1080x810
弥漫大b细胞淋巴瘤
图片尺寸697x524
淋巴细胞lymphocyte
图片尺寸907x443
淋巴细胞系形态识别ppt
图片尺寸1080x810
病例t细胞大颗粒淋巴细胞白血病
图片尺寸610x439
各种淋巴细胞及其它细胞
图片尺寸2000x2666